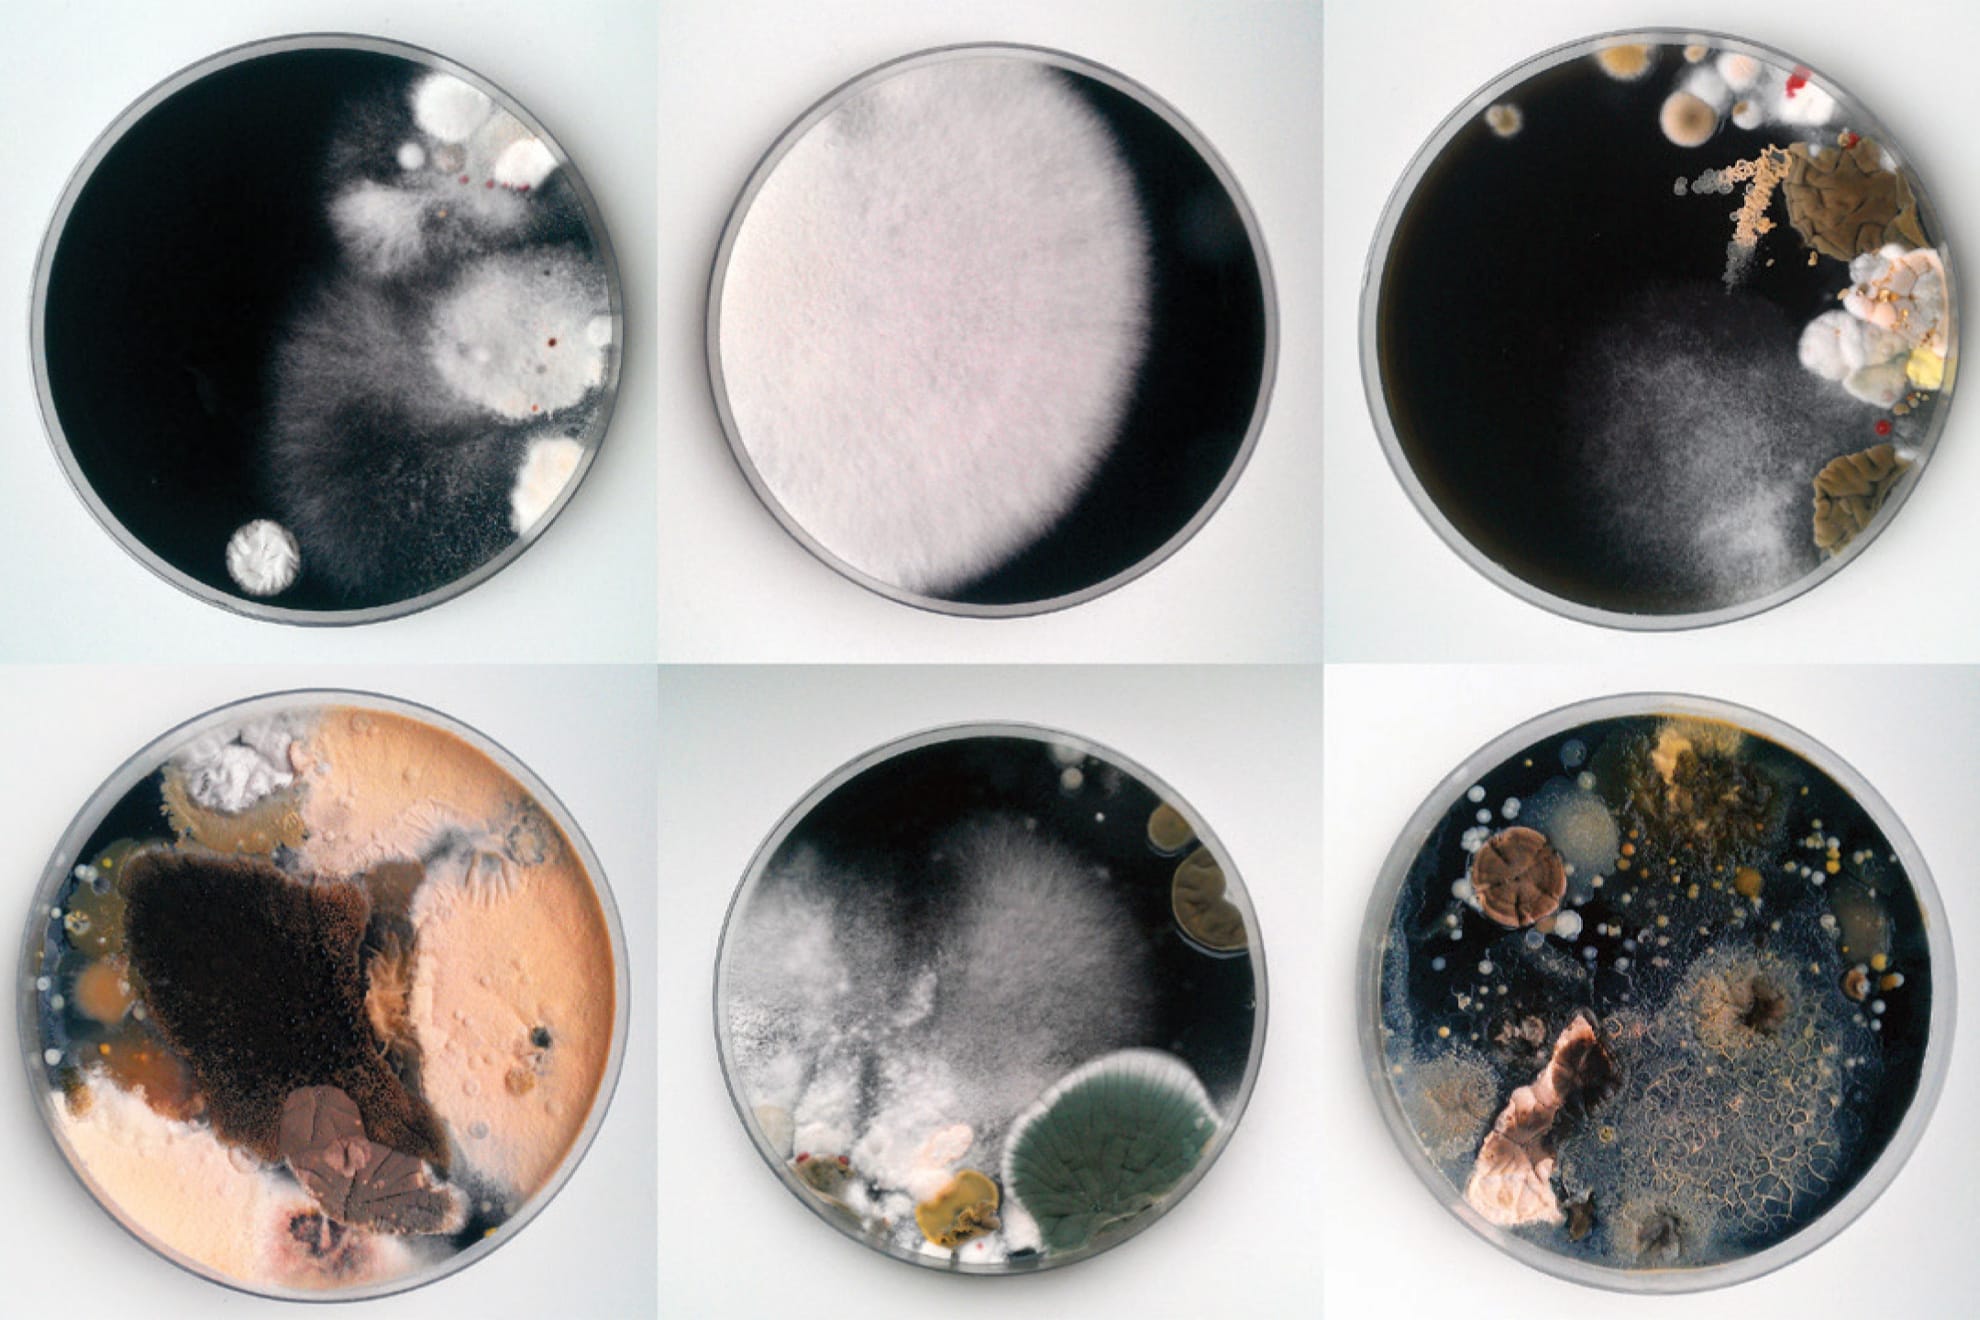

Nonhuman Subjectivities
The Other Selves. On the Phenomenon of the Microbiome
François-Joseph Lapointe | Saša Spačal with Mirjan Švagelj & Anil Podgornik | Tarsh Bates | Joana Ricou
Art Laboratory Berlin is pleased to present the new series Nonhuman Subjectivities. Based on current philosophical theories of the object and a critique of anthropocentrism, our attention is focused on non-human actors.
The exhibition, the first of our new exhibition series Nonhuman Subjectivities, presents various artistic reflections on the complex microbial environment found on and within the human body. Scientists say that bacterial cells are as numerous as human cells in our body. The phenomenon of the microbiome also brings forth many complex questions about human identity and our relation to our multiple selves.
François-Joseph Lapointe connects his biological research with performance art. His latest works of art deal with the microbiome in our daily lives and physical connections to others. Lapointe sequences his microbiome to produce metagenomic self-portraits, Microbiome Selfies, which illustrate the metamorphosis of his bacterial self.
The exhibition features new works from his performance in 1000 Handshakes which was realised on 3 February, 2016, the opening night of transmediale. During the evening Lapointe shook 1001 hands at the Berlin House of World Cultures. Every 50 or so handshakes, samples were collected from his palms for DNA analysis of the microbiome. The results demonstrate how the contact with others shapes our microbiome and changes us.
To create his artistic works Lapointe has used a next generation sequencing platform and network visualisation software developed for bioinformatics. In contrast to the analog microscopic analysis of previous generations, Lapointe is working here with a digital DNA record. Both the video work and the six prints constitute the final step of the analysis: the network analysis, It is noteworthy that Lapointe, in his artistic aesthetic production, deletes the systemic context (numbers, data). The pictures show a microbial profile during the interaction with the microbiomes of others. It is fascinating to think back to the essential gesture of his performance: the handshake, a basic and ancient act of networking.
Saša Spačal together with Mirjan Švagelj and Anil Podgornik are interested in the contrast between the oneness of the human body as biological entity and the multiplicity of the human microbiome. In their installation Mycophone_unison the artist-scientist-designer collective has developed a sound map of intra-action between their microbiomes and the recipient. By leaving a fingerprint the viewer sends a signal to the map that processes it through the central ‘celestial plate’ to the microbiomes. The polymodal sonification stresses the multiplicities of the makers.
The three petri dishes on the ‘celestial plate’ are cultured with samples from the work’s three creators. These cultures, in their multiplicity and complexity, defy any monolithic or unitary definition of being. But in their ever-changing resistance to an electrical current, these cultures microbiomes create, together, a unison of tone with the participatory aid of visitors.
Joana Ricou’s works blur the fundamental boundary between organism and environment, taking the shape of photographs of microbial paintings or performance. Ricou collected samples of her own microbiome and that of her environment and cultured these in the lab to visualise them. Out of this two portraits emerged: Other-self Portrait, a composite of cultures derived from her body, and Non-self Portrait, a composite of environmental cultures. Ricou, an émigré, began this work questioning whether her new environment was changing her microbiome, and if so, asking what is the border between self and ‘non-self’.
Her series Other Selves is a series of microbiome portraits that Ricou has carried out over the last few years, in which she has cultured samples from the belly buttons of over 400 people, resulting in an amazingly diverse range of bacteria, fungi and archaea. These portraits, in turn, challenge our traditional view of the self as solitary, or solely human.
Tarsh Bates artistically explores what it means to be human when we recognise our bodies as composed of over one trillion cells, of which only around half are human. This new work Surface dynamics of adhesion, created here in Berlin, resembles a model of flocked wallpaper. Sealed in a series of acrylic boxes in agar based on the blood of the artist, living Candida parapsilosis grows in a pattern based on the first drawing of its relative, Candida albicans, by Charles Philippe Robin in 1853. It was also the Victorian era when awareness of hygiene was rapidly increasing. This complex installation includes furniture from that time and invites visitors to sit down and read more about Tarsh Bates and her artistic research on Candida.
Her video work Ereignis, Gelassenheit und Lichtung: A love story shows, in time-lapse video, Candida albicans developing in the laboratory, whilst mixing with serum collected from the artist.
Regine Rapp & Christian de Lutz
Press Reviews
BODY // Nonhuman Subjectivities: Humans Can Learn from the Political Make-Up of Our Bacteria by Alice Bardos in berlinartlink.com
BioArt : What is our True Relationship with the Human Microbiome? by Claire Brown in labiotech.eu
BioArt: Joana Ricou shows the Beautiful Similarities of the Microbiome by Denise Neves Gameiro in labiotech.eu
Die Kunst des Händeschüttelns. Eine neue Ausstellung bei Art Laboratory Berlinn by Inge Pett in art-in-berlin-de
The beauty in your BELLY BUTTON: Artist uses fluff and bacteria from navels to create works of art that are ‘unique as fingerprints by Abigail Beall in The Daily Mail
Poleti bi lahko brstela v triindvajsetih identitetah by by Mojca Kumerdej in Delo
Your Belly Button Lint Makes a Beautiful Portrait as Unique as Your Fingerprint by Jennifer Ouellette in gizmodo.co
Petri Dish Portraits Of The Belly Button’s Bacteria by Tom Hale in iflscience!
Navel gazing: portraits of the bacteria in our belly buttons – in pictures in the Guardian
Cultural File: Hacking a Microbiome by Luke Clancy for RTE (Radio Television Ireland) as .mp3 (from 2’22”)
Haus der Kulturen der Welt: Künstler will 1000 hände schütteln by Philipp Pohl in
BZ- Berlin